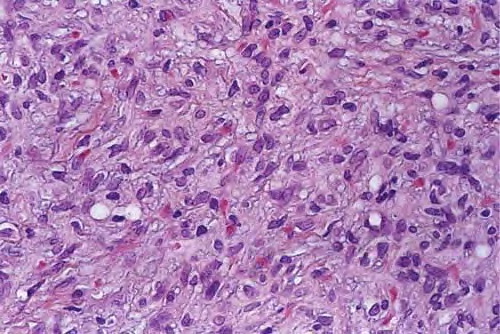

Epidermolysis bullosa acquisita = انحلال البشرة الفقاعي المكتسب
Epidermolysis bullosa acquisita = انحلال البشرة الفقاعي المكتسب Epidermolysis Bullosa Acquisita Classically, EBA is a noninherited disorder of acquired skin fragility. This presentation of EBA was the only one recognized until later. Blisters develop on noninflammatory bases with a predilection for acral areas. Scarring and milia formation ensue. A characteristic nail dystrophy and alopecia are […]
Read More